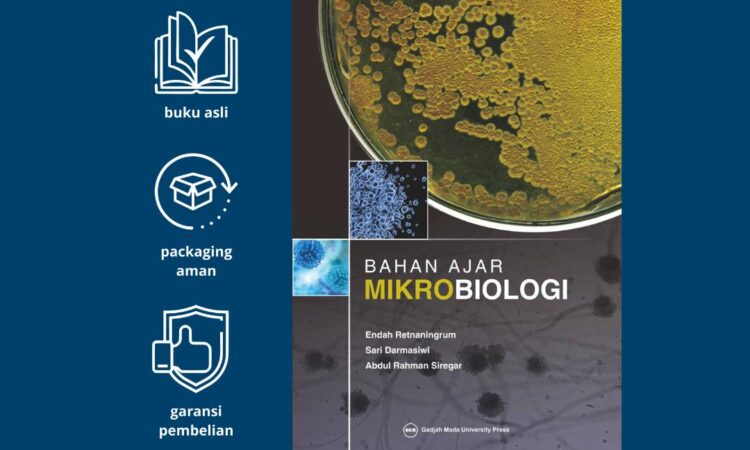

Penulis: Endah Retnaningrum, Sari Darmasiwi, Abdul Rahman Siregar
ISBN: 978-602-386-175-0
Cetakan Ketiga, April 2021
Tebal: 168 halaman
Ukuran: 15,5 cm x 23 cm
Sampul: Soft Cover
Penerbit: Gadjah Mada University Press
| Keunggulan Buku | Deskripsi |
|---|---|
| Referensi Terpercaya | Disusun oleh akademisi ahli dari Fakultas Biologi UGM untuk memastikan kedalaman dan keakuratan ilmu. |
| Materi Komprehensif | Membahas konsep dasar teoretis mikrobiologi secara lengkap dan terstruktur untuk pemula. |
| Bahasa Indonesia yang Jelas | Mengatasi keterbatasan pustaka mikrobiologi berbahasa Indonesia yang masih langka. |
| Persiapan Perkuliahan | Membantu mahasiswa mempersiapkan diri menghadapi perkuliahan dan mendalami pustaka terkait. |
| Dasar Ilmu Lanjutan | Menjadi pondasi kuat untuk mempelajari cabang mikrobiologi lain, seperti industri, kesehatan, dan lingkungan. |
| Fisika Buku Nyaman | Ukuran compact dan soft cover membuatnya mudah dibawa dan digunakan untuk belajar kapan saja. |
Buku ini adalah investasi terbaik untuk kesuksesan akademik Anda dalam menjelajahi dunia mikrobia yang menakjubkan.
Definisi:
- Mikrobia/Mikroba: Organisme hidup yang berukuran sangat kecil (mikroskopis) dan hanya dapat dilihat dengan menggunakan mikroskop. Contohnya adalah bakteri, virus, jamur mikroskopis, dan protozoa.
- Mikrobiologi: Cabang ilmu biologi yang mempelajari tentang mikroorganisme, termasuk struktur, fungsi, peran, dan pemanfaatannya dalam kehidupan.
Informasi Lebih Lanjut dan Pembelian klik di sini.